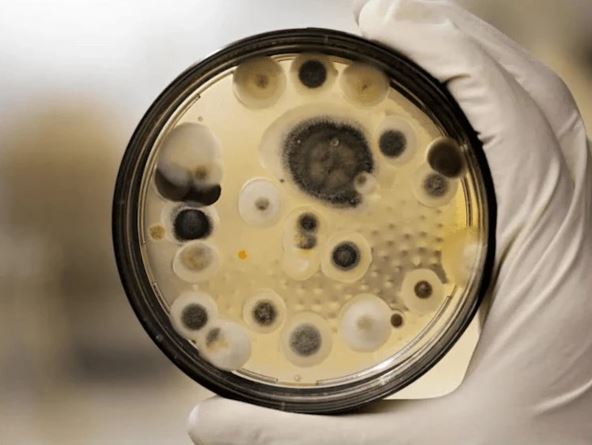

مہلک فنگس کا تیزی سے پھیلاؤ،ماہرین نے خبردار کر دیا
مہلک فنگس، جس کا نام ایسپرجیلوس ہے، اب پہلے سے کہیں زیادہ خطرناک اور تیزی سے پھیلتا ہوا دکھائی دے رہا ہے
لندن(ہیلتھ ڈیسک)ایک مہلک فنگس، جس کا نام ایسپرجیلوس ہے، اب پہلے سے کہیں زیادہ خطرناک اور تیزی سے پھیلتا ہوا دکھائی دے رہا ہے، اور اس کا نشانہ صرف انسان ہی نہیں، جانور اور پودے بھی ہیں۔
یہ فنگس انسانوں میں ایسپرجیلوسس نامی بیماری کا باعث بنتا ہے، جو پھیپھڑوں پر حملہ کرتی ہے اور جان لیوا ثابت ہو سکتی ہے۔ برطانیہ کی مانچسٹر یونیورسٹی کے سائنسدانوں نے خبردار کیا ہے کہ موسمیاتی تبدیلیوں کے باعث دنیا کے درجہ حرارت میں جو اضافہ ہو رہا ہے، وہ اس مہلک فنگس کیلیے نئے دروازے کھول رہا ہے۔ اب یہ مائیکروبس ان علاقوں کی طرف بڑھ رہا ہے جہاں اس کا وجود پہلے ممکن نہیں تھا، جیسے شمالی امریکا، یورپ، چین اور روس۔
تحقیق کے مطابق، ایسپرجیلوس کی بعض اقسام ماحولیاتی سپروٹروف کہلاتی ہیں، جو نہ صرف انسانی جسم بلکہ جانوروں اور پودوں میں بھی خطرناک انفیکشنز پیدا کرسکتی ہیں۔ اس تحقیق کو اگرچہ اب بھی سائنسی جانچ پڑتال یعنی peer review سے گزرنا باقی ہے، مگر اس کے نتائج نے عالمی طبی برادری کو ہلا کر رکھ دیا ہے۔
محقق نورمن وین رائن، جو موسمیاتی تبدیلی اور متعدی امراض کے ماہر ہیں، کہتے ہیں کہ فنگس وائرس اور بیکٹیریا کی طرح خطرناک ہیں، لیکن ان پر تحقیق کم ہوئی ہے۔ انہوں نے HBO کی مشہور سیریز The Last of Us کا حوالہ دیا، جس میں ایک فنگس انسانوں کو خوفناک مخلوق میں بدل دیتا ہے۔ ان کے مطابق، اگرچہ حقیقی زندگی میں ایسا منظرنامہ بعید از قیاس ہے، لیکن اس فکشن نے کم از کم دنیا کو فنگل انفیکشنز کی سنگینی سے متعارف تو کرایا ہے۔
حقیقت یہ ہے کہ ہر سال لگ بھگ 25 لاکھ افراد فنگس سے پیدا ہونے والی بیماریوں کے باعث ہلاک ہو جاتے ہیں، اور اصل تعداد شاید اس سے بھی کہیں زیادہ ہو کیونکہ اس حوالے سے ڈیٹا کی شدید کمی ہے۔ ایسپرجیلوس زمین میں باریک ریشوں کی شکل میں اگتا ہے اور لاکھوں کی تعداد میں چھوٹے چھوٹے اسپورز پیدا کرتا ہے جو ہوا میں شامل ہو کر آسانی سے انسانوں کے سانس کے ذریعے جسم میں داخل ہو جاتے ہیں۔
عام طور پر ہمارا مدافعتی نظام انہیں ختم کر دیتا ہے، لیکن جن افراد کا مدافعتی نظام کمزور ہو، جیسے دمے، سسٹک فائبروسس، کینسر، یا اعضا کی پیوندکاری کے مریض، ان کے لیے یہ اسپورز موت کا پیغام بن سکتے ہیں۔
نورمن وین رائن واضح کرتے ہیں کہ جب فنگس جسم کے اندر قدم جما لیتا ہے، تو وہ واقعی آپ کو اندر سے کھانے لگتا ہے۔ اور المیہ یہ ہے کہ اس بیماری کی علامات، بخار، کھانسی، تھکن، اتنی عام ہیں کہ اکثر اس کی تشخیص بروقت نہیں ہو پاتی۔ یہی وجہ ہے کہ ایسپرجیلوسس کی اموات کی شرح 20 سے 40 فیصد تک پہنچ جاتی ہے۔
یہ ایک ایسا خطرہ ہے جو نہ نظر آتا ہے، نہ آواز دیتا ہے مگر خاموشی سے جسم کے اندر داخل ہو کر تباہی مچا دیتا ہے۔ اس کے خلاف لڑائی کا پہلا قدم ہے آگاہی۔ اور شاید اب وقت آ گیا ہے کہ ہم فنگس کو صرف دیواروں پر اگنے والی پھپھوندی نہ سمجھیں، بلکہ ایک حقیقی عالمی خطرہ تسلیم کریں۔



